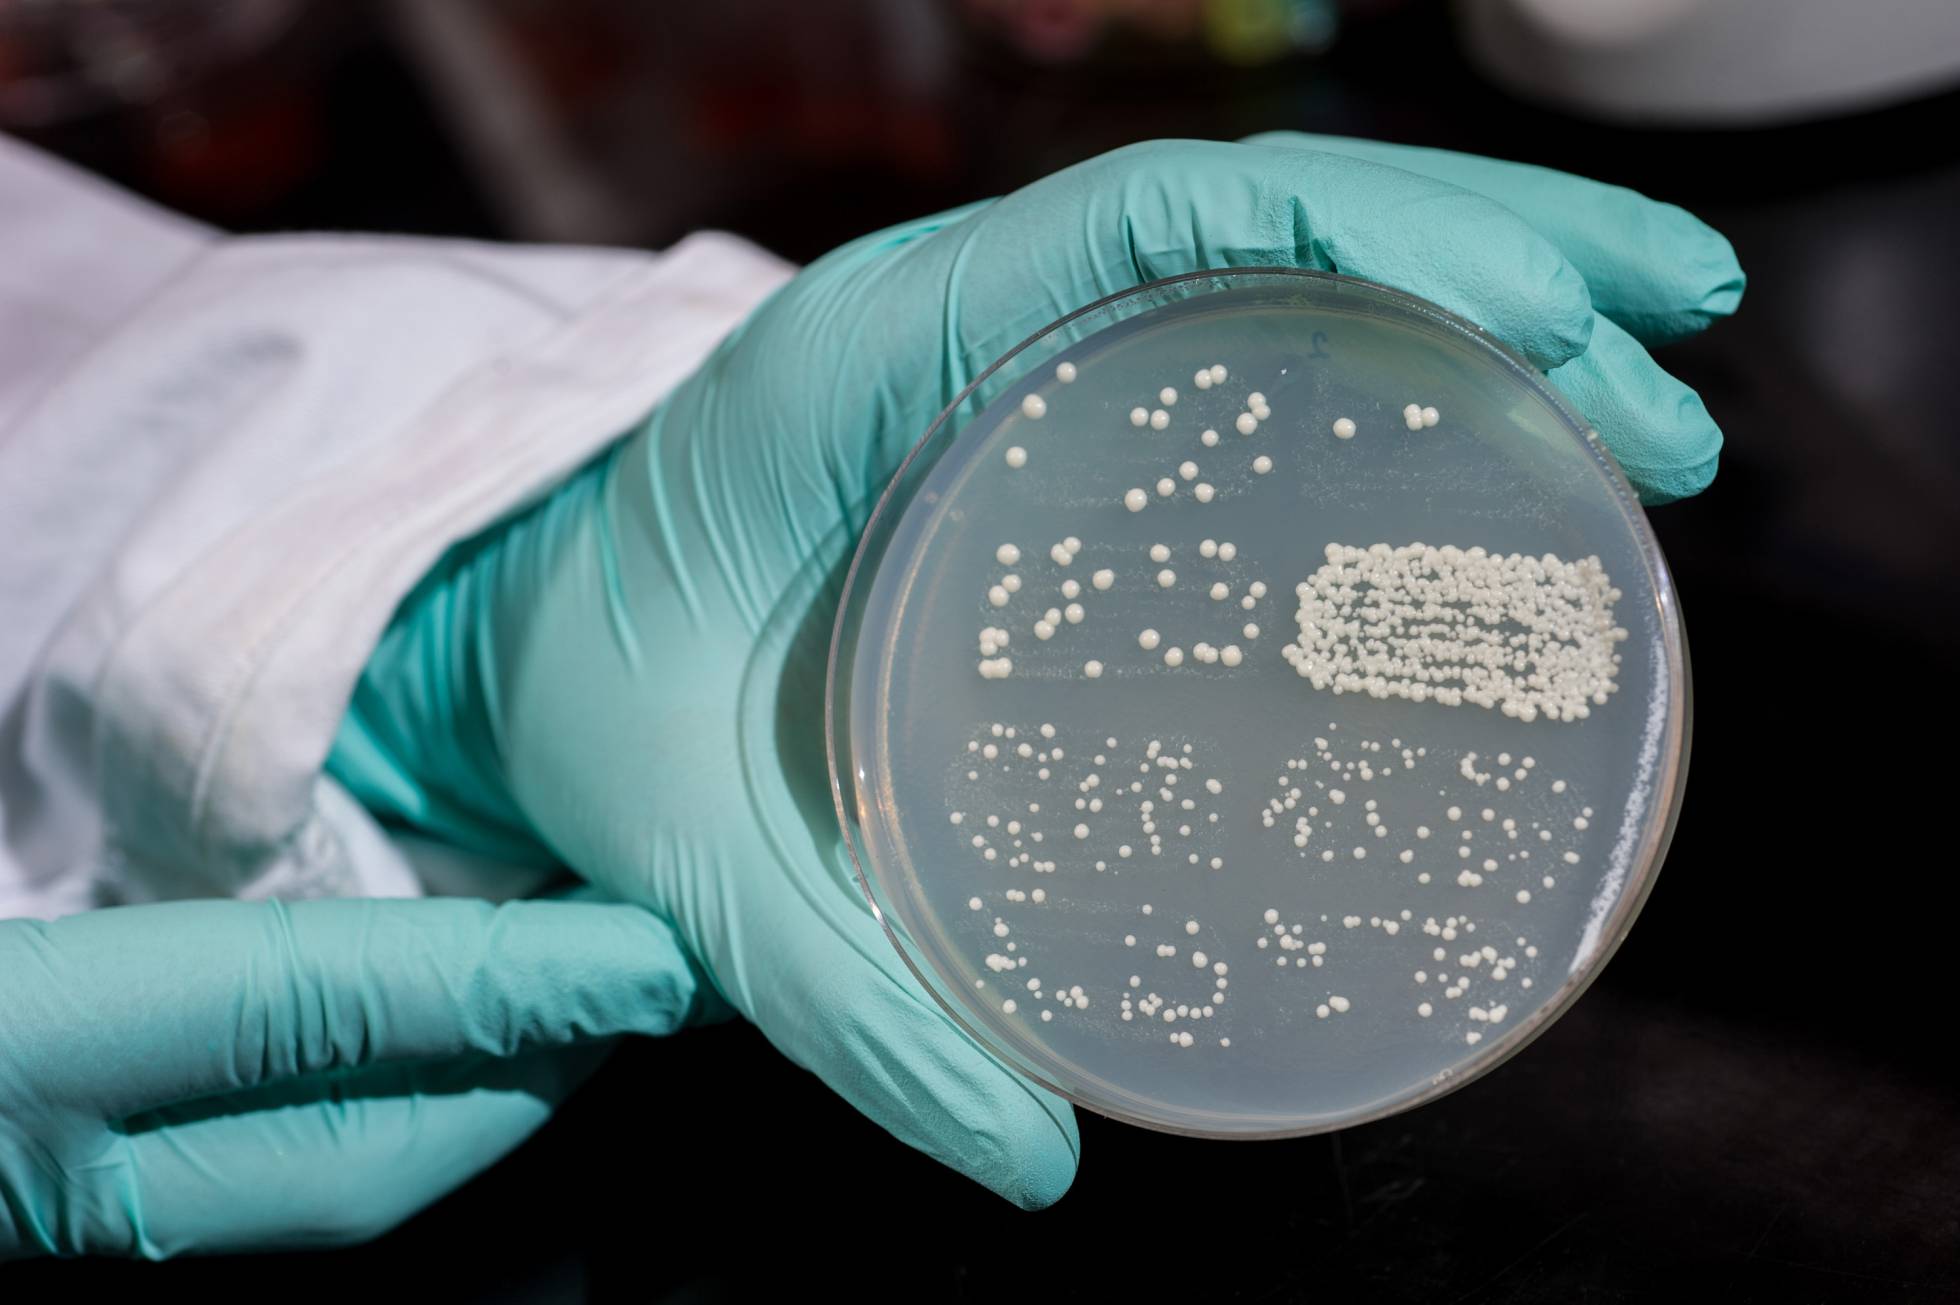
Un cultivo de levadura.

La síntesis de 6 de los 16 cromosomas de la levadura, una célula compleja como las nuestras, abre un nuevo camino hacia la creación de medicamentos, biocombustibles sostenibles y nuevas terapias
Las cifras apabullan. Cinco cromosomas de levadura sintéticos, 200 científicos de diez universidades y la promesa realista de construir, en solo unos años, una célula humana con un genoma enteramente diseñado en un ordenador. Contra lo que suele decirse, sin embargo, las cifras no lo dicen todo, ni explican nada sobre el fondo de la cuestión: el por qué, el para qué y el cómo. Ese es el objetivo de este artículo lleno de palabras.
El por qué ya lo enunció el gran físico Richard Feynman, aunque en un contexto muy distinto: si no puedo crearlo, es que no lo entiendo. De las varias élites de la ciencia, una de las más importantes está empeñada en la biología sintética: en construir seres vivos para entenderlos por completo. Y también para utilizarlos para poderosas e innovadoras aplicaciones tecnológicas: nuevos antibióticos y fármacos, biocombustibles más sostenibles, terapias génicas no ya de un gen defectuoso, sino de un completo circuito genético inconveniente para la salud.
El pionero privado del genoma humano, Craig Venter, lo fue también del campo emergente de la biología sintética, al crear en 2010 la primera célula artificial, una bacteria llamada Mycoplasma mycoides JCVI-syn1.0 cuyos 473 genes habían salido por entero de “cuatro botes de productos químicos del laboratorio”, como dijo el científico con intrepidez característica. Las bacterias son células, en efecto, pero de una complejidad mucho menor que las nuestras. El genoma humano tiene unos 20.000 genes, o 40 veces más que el micoplasma. Nuestras células son eucariotas, formadas formadas por la asociación de varias bacterias y evolucionadas a partir de ahí durante 2.000 millones de años, la mitad de la historia de la vida en la Tierra
Cuando un científico quiere estudiar la biología humana, nunca empieza por investigar las células humanas –eso es lento, inconveniente e ineficaz—, sino las células eucariotas más simples y prácticas, que son las levaduras. La levadura Saccharomyces cerevisiae constituye seguramente la biotecnología más antigua de la historia, utilizada desde hace milenios para fabricar el pan y la cerveza, y desde hace unas décadas para producir medicamentos y biocombustibles. Fue el primer eucariota del que se secuenció el genoma, y pronto será el primero en exhibir un genoma enteramente sintético.
Un consorcio internacional dirigido por Jef Boeke, de la facultad de medicina de la Universidad de Nueva York, Srinivasan Chandrasegaran, de la Universidad de Stanford, y Joel Bader, de la Johns Hopkins, y en el que colaboran científicos chinos, británicos y franceses, presenta en siete artículos técnicos de la revista Science la proeza de haber sintetizado (a partir de cuatro botes, como diría Venter) cinco cromosomas de la levadura. Junto al primero, que se presentó en 2014, ya hacen 6 de los 16 cromosomas de ese organismo eucariota, o un tercio de su genoma. El resto, según calculan, estará listo antes de que acabe el año. LEER MÁS.
No hay comentarios:
Publicar un comentario